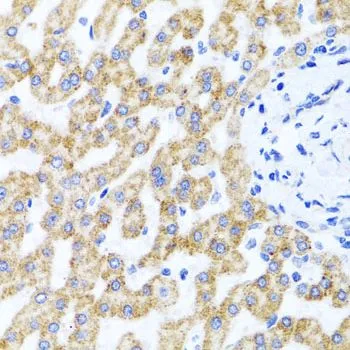

IHC-P analysis of human liver damage tissue using GTX64956 RIPK4 antibody. Dilution : 1:100
RIPK4 antibody
GTX64956
ApplicationsWestern Blot, ImmunoHistoChemistry, ImmunoHistoChemistry Paraffin
Product group Antibodies
ReactivityHuman
TargetRIPK4
Overview
- SupplierGeneTex
- Product NameRIPK4 antibody
- Delivery Days Customer9
- Application Supplier NoteWB: 1:500 - 1:2000. IHC-P: 1:100 - 1:200. *Optimal dilutions/concentrations should be determined by the researcher.Not tested in other applications.
- ApplicationsWestern Blot, ImmunoHistoChemistry, ImmunoHistoChemistry Paraffin
- CertificationResearch Use Only
- ClonalityPolyclonal
- ConjugateUnconjugated
- Gene ID54101
- Target nameRIPK4
- Target descriptionreceptor interacting serine/threonine kinase 4
- Target synonymsANKK2, ANKRD3, CHANDS, DIK, NKRD3, PKK, PPS2, RIP4, receptor-interacting serine/threonine-protein kinase 4, PKC-delta-interacting protein kinase, ankyrin repeat domain-containing protein 3, protein kinase C-associated kinase, serine/threonine-protein kinase ANKRD3
- HostRabbit
- IsotypeIgG
- Scientific DescriptionThe protein encoded by this gene is a serine/threonine protein kinase that interacts with protein kinase C-delta. The encoded protein can also activate NFkappaB and is required for keratinocyte differentiation. This kinase undergoes autophosphorylation. [provided by RefSeq, Jul 2008]
- ReactivityHuman
- Storage Instruction-20°C or -80°C,2°C to 8°C
- UNSPSC41116161





